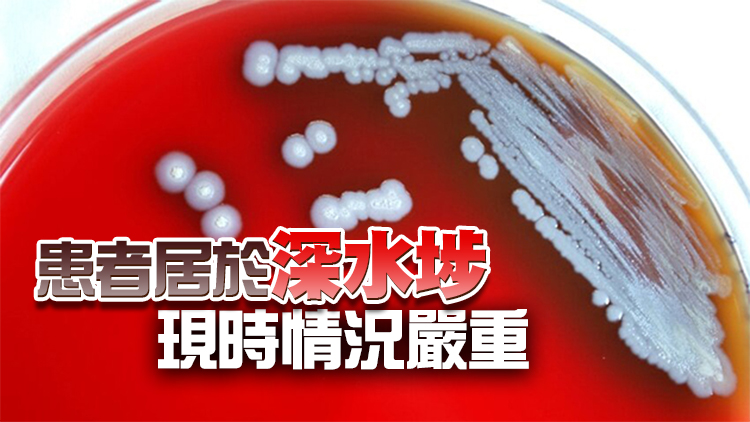
再多一名83歲男子感染類鼻疽 白田邨重建地盤4泥土樣本呈陽性

英國首相卓慧思辭職後,執政保守黨下周選舉新黨魁,勝出者將接任首相。保守黨下議院領袖莫佩琳21日率先宣布參與角逐。
莫佩琳在社交網站發文指,對獲得同僚的支持感到鼓舞,他們希望有一個新開始,一個團結的政黨以及符合國家利益的領導,她決定參選黨魁,以團結國家、兌現保守黨的承諾,以及帶領黨贏得下屆大選。英國傳媒預期,前財相辛偉誠及前首相約翰遜亦會參選。
據Skynews報道,莫佩琳在今年夏天的黨魁選舉,去到第5輪投票,得票第3被淘汰。她其後轉為支持卓慧思,在卓慧思9月當選黨魁接任首相後,獲任命為下議院領袖。報道指,莫佩琳又與財相侯俊偉會晤,指自己一旦勝選上台,侯俊偉將獲留任財相,並可如期在本月31日公布中期預算案。(路透社圖片)